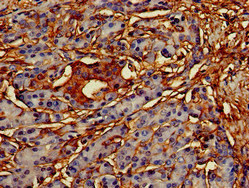
Immunohistochemistry of paraffin-embedded human pancreatic tissue using CSB-PA856900LA01HU at dilution of 1:100 Immunohistochemistry of paraffin-embedded human pancreatic tissue using CSB-PA856900LA01HU at dilution of 1:100

Immunohistochemistry of paraffin-embedded human liver cancer using CSB-PA856900LA01HU at dilution of 1:100
CREB3L1 Antibody
CSB-PA856900LA01HU
ApplicationsImmunoFluorescence, Western Blot, ELISA, ImmunoHistoChemistry
Product group Antibodies
ReactivityHuman, Mouse, Rat
TargetCREB3L1
Overview
- SupplierCusabio
- Product NameCREB3L1 Antibody
- Delivery Days Customer20
- ApplicationsImmunoFluorescence, Western Blot, ELISA, ImmunoHistoChemistry
- CertificationResearch Use Only
- ClonalityPolyclonal
- ConjugateUnconjugated
- Gene ID90993
- Target nameCREB3L1
- Target descriptioncAMP responsive element binding protein 3 like 1
- Target synonymsC16DELp11.2, DEL16p11.2, OASIS, OI16, cyclic AMP-responsive element-binding protein 3-like protein 1, BBF-2 homolog, Osteogenesis imperfecta, type XVI, cAMP-responsive element-binding protein 3-like protein 1, old astrocyte specifically-induced substance
- HostRabbit
- IsotypeIgG
- Protein IDQ96BA8
- Protein NameCyclic AMP-responsive element-binding protein 3-like protein 1
- Scientific DescriptionTranscription factor involved in unfolded protein response (UPR). In the absence of endoplasmic reticulum (ER) stress, inserted into ER membranes, with N-terminal DNA-binding and transcription activation domains oriented toward the cytosolic face of the membrane. In response to ER stress, transported to the Golgi, where it is cleaved in a site-specific manner by resident proteases S1P/MBTPS1 and S2P/MBTPS2. The released N-terminal cytosolic domain is translocated to the nucleus to effect transcription of specific target genes. Plays a critical role in bone formation through the transcription of COL1A1, and possibly COL1A2, and the secretion of bone matrix proteins. Directly binds to the UPR element (UPRE)-like sequence in an osteoblast-specific COL1A1 promoter region and induces its transcription. Does not regulate COL1A1 in other tissues, such as skin (By similarity). Required to protect astrocytes from ER stress-induced cell death. In astrocytes, binds to the cAMP response element (CRE) of the BiP/HSPA5 promoter and participate in its transcriptional activation (By similarity). May play a role in limiting virus spread by inhibiting proliferation of virus-infected cells. Upon infection with diverse DNA and RNA viruses, inhibits cell-cycle progression by binding to promoters and activating transcription of genes encoding cell-cycle inhibitors, such as p21/CDKN1A (PubMed:21767813). Binds the DNA consensus sequence 5-GTGXGCXGC-3 (PubMed:21767813).
- ReactivityHuman, Mouse, Rat
- Storage Instruction-20°C or -80°C
- UNSPSC41116161